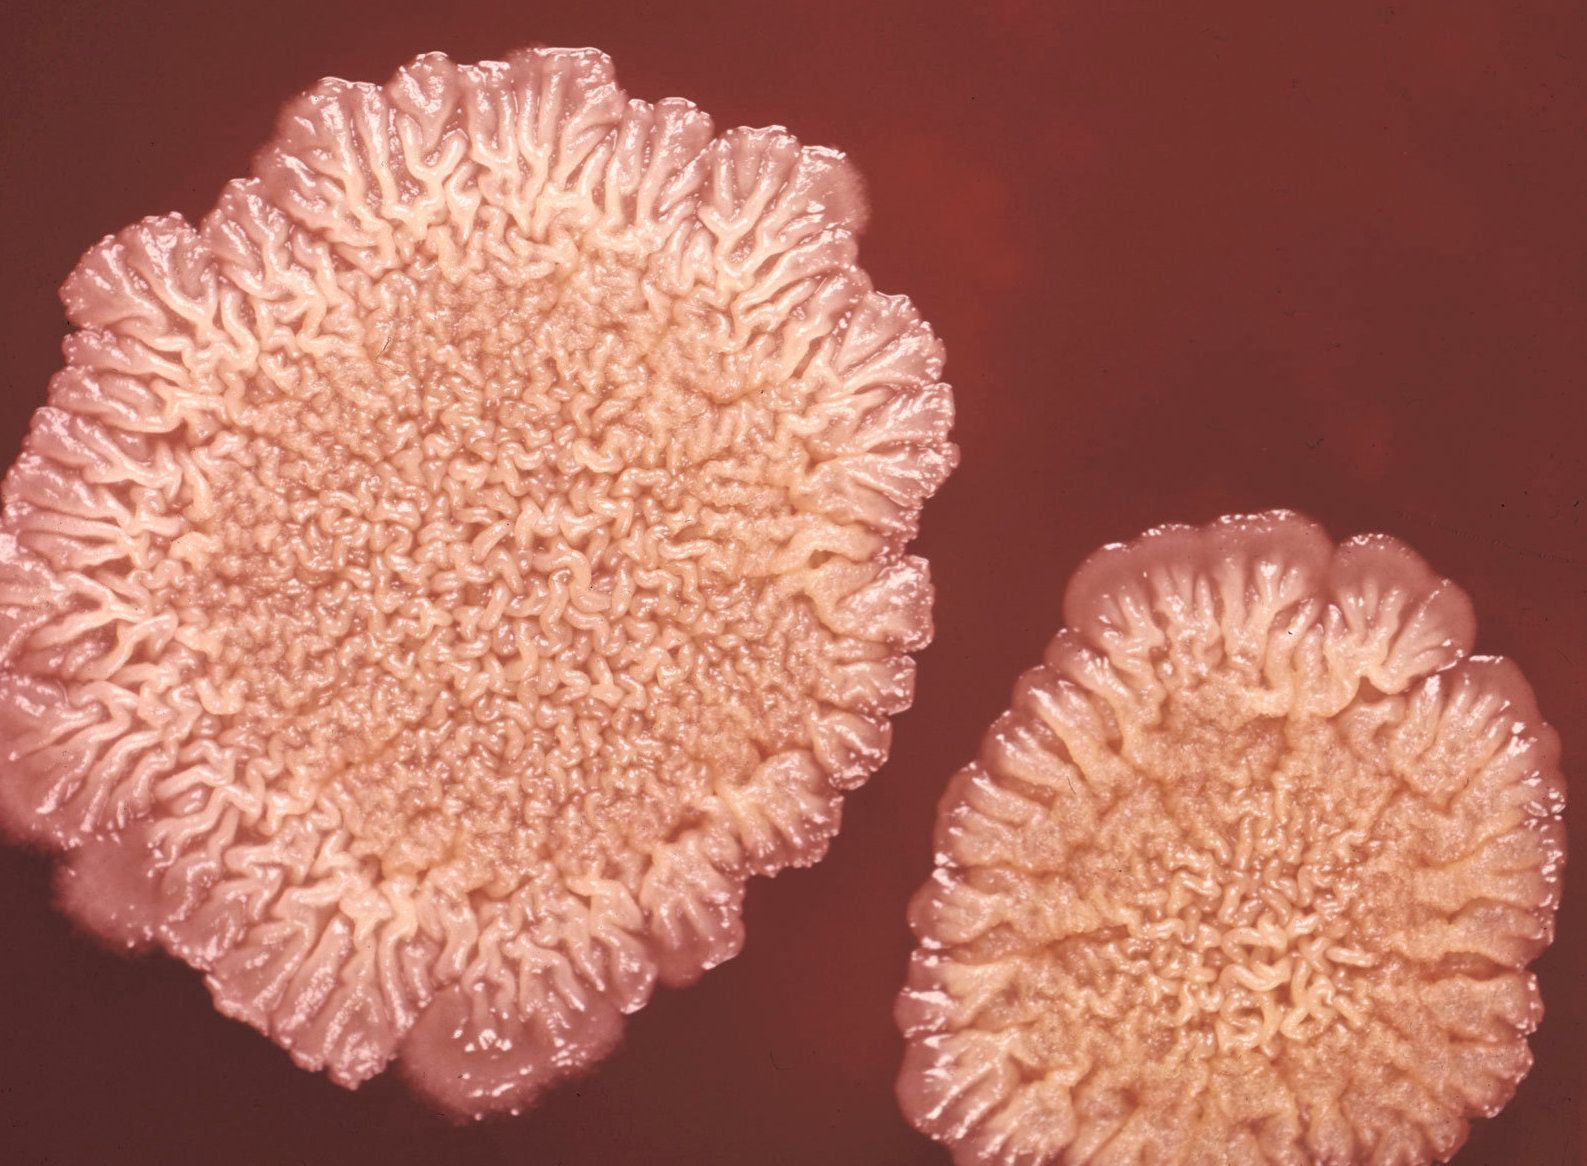

Bakterier har biologiske klokker
DØGNRYTME: Bakterier har indre klokker som justerer aktiviteten i rytme med jordas 24-timerssyklus. Dette gjelder også bakterier som ikke er fotosyntetiske, som ikke er avhengige av lys for å få energi. Britiske, danske og tyske forskere har studert bakterien Bacillus subtilis, som brukes til mange formål, fra vaskemidler til probiotika. De fant at døgnrytmen kunne justeres med endring av lysforholdene, og tenker at oppdagelsen kan nyttiggjøres blant annet i medisinsk behandling. (Science Advances) BV
Du må være abonnent for å lese denne artikkelen
Allerede abonnent? Logg inn
